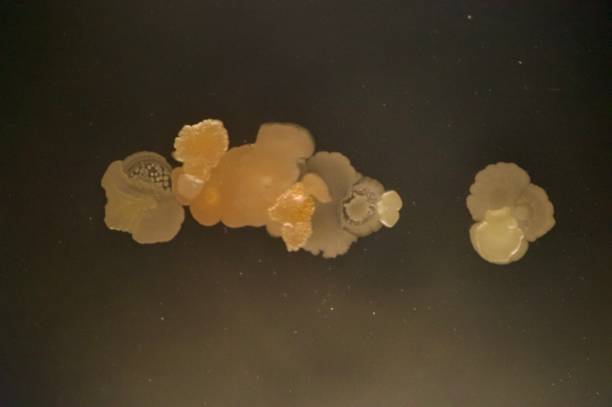
中马吉孕：rb1基因可以通过试管筛查？

中马吉孕:试管胚胎激活多久移植看受精结果?
愛之晶海外國際醫療轉介有限公司 中马吉孕 海外转诊试管助孕医疗服务二代试管胚胎激活后的移植时间,要看胚胎是否...
阅读详情电话:19919999145
微信:17027022222
邮箱:kf@daiyun.cn
地址:国内、马来西亚、吉尔吉斯斯坦
试管婴儿医院 第3页

愛之晶海外國際醫療轉介有限公司 中马吉孕 海外转诊试管助孕医疗服务二代试管胚胎激活后的移植时间,要看胚胎是否...
阅读详情
愛之晶海外國際醫療轉介有限公司 中马吉孕 海外转诊试管助孕医疗服务正常情况下,rb1基因可以通过三代试管筛查...
阅读详情
愛之晶海外國際醫療轉介有限公司 中马吉孕 海外转诊试管助孕医疗服务24岁女性做试管选择短方案,不一定合适。正...
阅读详情
愛之晶海外國際醫療轉介有限公司 中马吉孕 海外转诊试管助孕医疗服务第一代试管是有可能选择出A级精子的,但是并...
阅读详情
愛之晶海外國際醫療轉介有限公司 中马吉孕 海外转诊试管助孕医疗服务大部分夫妻对试管婴儿有抵触是很正常的,这是...
阅读详情
愛之晶海外國際醫療轉介有限公司中马吉孕海外转诊试管助孕医疗服务三代试管冷冻精子可以保存10年甚至更久的时间,但是在储存过程中使用...
阅读详情
愛之晶海外國際醫療轉介有限公司中马吉孕海外转诊试管助孕医疗服务二代试管婴儿怀双胞胎的情况下,一般是同性双胞胎居多,在双胞胎的基础...
阅读详情
愛之晶海外國際醫療轉介有限公司中马吉孕海外转诊试管助孕医疗服务36岁试管婴儿可以一次移植2个胚胎,一般来说,试管婴儿移植多少个胚...
阅读详情
愛之晶海外國際醫療轉介有限公司中马吉孕海外转诊试管助孕医疗服务hcg翻倍慢、孕囊偏小有可能是胚胎发育异常引起的,甚至是胚胎停育的...
阅读详情
试管卵泡只有13mm打夜针是有可能成熟的,本身打夜针就是促进卵泡的成熟,打完之后部分12mm到13mm的小卵泡还会继续生长发育一...
阅读详情
37岁女性做试管婴儿可以选择第一代试管,但是鉴于高龄女性胚胎非整倍体发生率高,而这又是导致胚胎反复种植失败、自然流产的重要原因之...
阅读详情
中马吉孕三代试管最佳移植时间? 第三代试管婴儿移植最好的时间因人而异,...
阅读详情
中马吉孕冻囊胚解冻后可以做三代基因筛查吗? 冻囊胚可以做三代基因筛查,...
阅读详情
中马吉孕cd138细胞子宫内膜炎不能做试管?正常情况下,cd138细胞子宫内膜炎是不建议做试管婴儿的,因为内膜炎症会导致子宫内膜...
阅读详情
中马吉孕三代试管胚胎缺陷强行移植有什么问题?三代试管胚胎缺陷强行移植会出现很多问题,尤其是对女性的身体造成影响、胚胎移植后先兆流...
阅读详情
中马吉孕使用来曲唑片促排容易怀双胞胎?试管使用来曲唑片来促排卵是容易怀双胞胎,而且使用来曲唑促排卵的女性出现双胞胎的...
阅读详情
中马吉孕习惯性流产可以做试管吗?大部分情况下,习惯性流产后都可以继续自然生育,但是继续生育之前一定要弄清楚导致多次流产的原因。当...
阅读详情
爱之晶海外试管助孕 中马吉孕试管移植冻胚只看子宫内膜吗?试管移植冻胚并不是只看子宫内膜,也要看女性激素水平,这两个条件...
阅读详情
中马吉孕三代试管婴儿筛查后也会不着床?三代试管婴儿筛查后的胚胎也会有不着床的情况,因为筛查后的胚胎并不是100%没有问题,就算没...
阅读详情
中马吉孕二代试管移植着床感觉不舒服正常吗? 二代试管移植着床感觉不舒服...
阅读详情
中马吉孕输卵管积水做第几代试管?输卵管积水一般都会建议做三代试管,不仅可以提高怀孕的成功率,还可以通过PGS、PGD...
阅读详情
爱之晶海外试管助孕 中马吉孕多囊卵巢适合做第几代试管婴儿?多囊卵巢和输卵管堵塞都适合做一代试管婴儿,它们都属于女性不孕...
阅读详情
一代试管胚胎养成囊胚后能进行胚胎检测,但是如果没有遗传病以及染色体异常等家族史或迹象,是没必要做胚胎检测的。也就是说,只有遗传病...
阅读详情
爱之晶海外试管助孕中马吉孕染色体异常做几代试管婴儿?染色体异常可以考虑通过三代试管婴儿来解决生育问题,目前三代试管婴儿可以对胚胎...
阅读详情
爱之晶海外试管助孕中马吉孕二代试管剩余胚胎可以冷冻二代试管有剩余的胚胎可以冷冻,但是需要满足冷冻胚胎的条件才可以冷冻,也就是卵裂...
阅读详情
爱之晶海外试管助孕 中马吉孕单侧输卵管切除影响试管成功率吗?单侧输卵管切除是不影响试管婴儿的成功率, 本身试管婴儿的精...
阅读详情
愛之晶海外國際醫療轉介有限公司中马吉孕海外转诊试管助孕医疗服务不管是自然怀孕还是试管婴儿,生男孩和女孩的概率其实各占50%。当然...
阅读详情
愛之晶海外國際醫療轉介有限公司中马吉孕海外转诊试管助孕医疗服务三代囊胚着床的成功率通常在40%-45%之间,但这也取决于个人情况...
阅读详情
多囊加输卵管通而不畅的情况下,不一定要做试管婴儿,因为多囊加输卵管通而不畅是可以治疗的,治疗后健康的几率很高,自然怀孕的几率也很...
阅读详情
试管婴儿能不能一定成功,关键并不在意夫妻的身体条件,本身做试管婴儿从来都不是一定会成功的,作为辅助生育技术,它受到多种因素的影响...
阅读详情